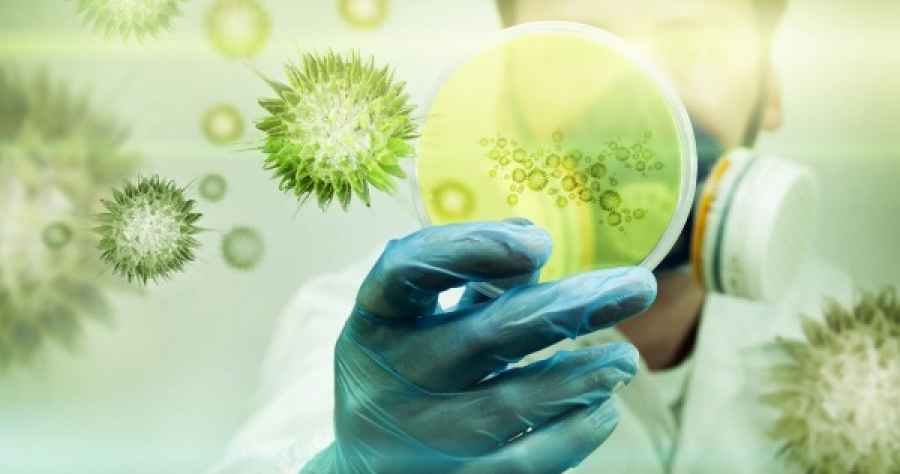
Nueva cepa: la gravedad no aumenta, pero se transmite un 70% m&aacute;s

Hoy en Revista Dosis
Más...
Lo más visto
- Covishield, la vacuna que India lanzó con Oxford-AstraZeneca
- El gobierno establece los requisitos para la producción de cannabis medicinal
- Anmat aprobó en el país la primera vacuna que protege contra el dengue
- Ibupirac declarado apto para celíacos
- Comunicación de Novo Nordisk: Diferencias en la indicación de Victoza® y Saxenda®